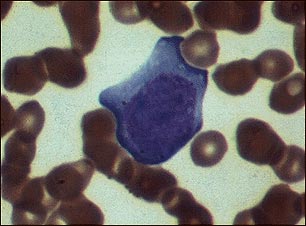
Mononucleosis, microfotograf&iacute;a de c&eacute;lulas

|  |  |
Mononucleosis, microfotografía de células
Este es un linfocito que ha sido infectado con el virus de Epstein-Barr (VEB) o citomegalovirus (CMV) en la mononucleosis infecciosa, y es comúnmente conocido como "célula de Downey". Las células de Downey tienen tres clasificaciones: tipo I, tipo II o tipo III. Esta es una célula de Downey tipo I.
Actualizado: 9/17/2008
